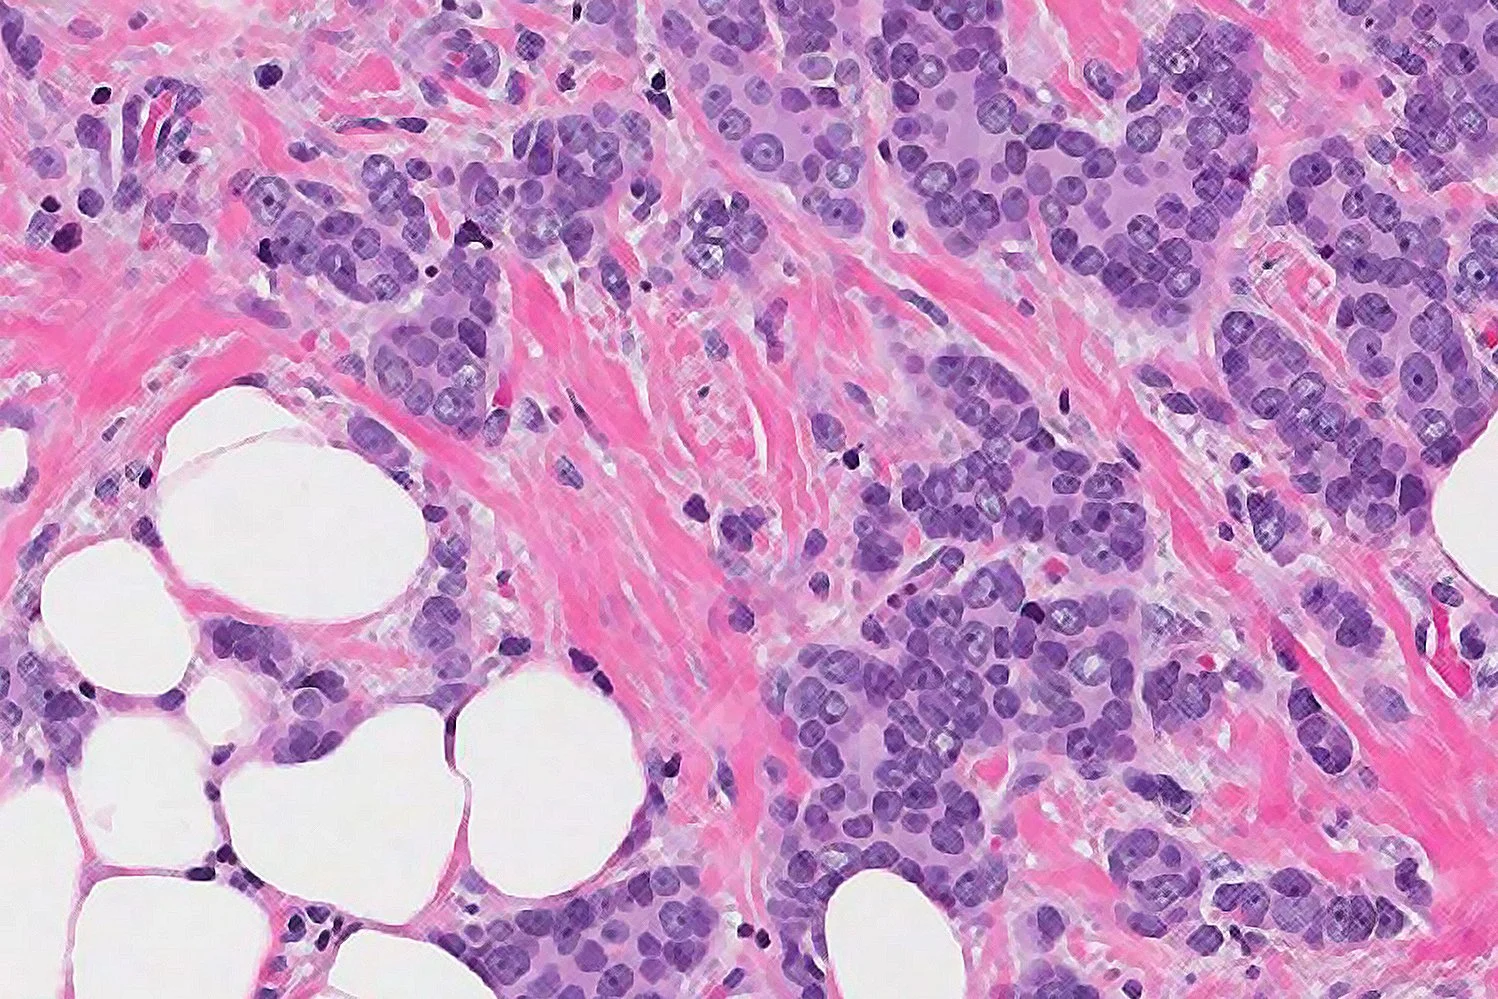
Focus : Vals alarm bij borstkanker

Vraag het de professor: webinar voor mensen met (doorgemaakte) borstkanker

Webinar woensdagavond 5 november, 19:30 20:30
Heeft u vragen over borstkanker? Tijdens dit digitale webinar neemt oncoloog Agnes Jager de tijd om in begrijpelijke taal antwoord te geven. Een avond speciaal voor patiënten en hun naasten. Stuur uw vraag gerust alvast in: we horen graag wat er bij u leeft.
WEBINAR (DIGITAAL)
Wanneer: woensdag 5 november
Hoe laat: 19:30 -20:30
Kosten: gratis
Inschrijven: via de knop hieronder (vóór 5 november ontvangt u de link om deel te nemen!)
Vragen: mogen nu al ingestuurd worden via onderstaande knop.
Meest recente berichten
Graag delen wij het event Share & Shine voor Stichting Voor Jou. Deze stichting ondersteunt vrouwen die kanker hebben of hebben gehad door middel van ontspanningsweekenden.
Dinsdag heeft het programma Focus een aflevering met de titel '𝘝𝘢𝘭𝘴 𝘢𝘭𝘢𝘳𝘮 𝘣𝘪𝘫 𝘣𝘰𝘳𝘴𝘵𝘬𝘢𝘯𝘬𝘦𝘳' met o.a. het onderwerp DCIS: 𝘋𝘶𝘤𝘵𝘢𝘢𝘭 𝘤𝘢𝘳𝘤𝘪𝘯𝘰𝘮𝘢 𝘪𝘯 𝘴𝘪𝘵𝘶. Focus is een wetenschapsjournalistiek programma.
Namens het volledige team van Borst Vooruit feliciteren wij Prof. dr. Agnes Jager met haar oratie! Van harte met deze bijzondere mijlpaal en wensen we je veel inspiratie en impact toe in je verdere werk.
Ons webinar van 5 november gaat niet door. We hebben gemerkt dat er binnen onze groep deelnemers verschillende behoeften zijn. Daarom kiezen we ervoor om onze webinars meer te richten op specifieke doelgroepen
Een waardevolle aanvulling zijn lotgenoten. Eerlijk gezegd vond ik dat altijd een stom woord. Het riep bij mij het beeld op van een groep mensen die alleen maar klagen en huilen over hun ziekte. Maar dat was een vooroordeel.
In de podcast Koekjes, Koffie en Kanker vertelt oncologisch verpleegkundige Paola Veenstra openhartig over haar werk en over wat er gebeurt als zorg verder gaat dan alleen protocollen en medische handelingen.
Heeft u vragen over borstkanker? Tijdens dit webinar neemt oncoloog Agnes Jager de tijd om in begrijpelijke taal antwoord te geven. Stuur uw vraag gerust alvast in: we horen graag wat er bij u leeft.
Onderzoekers van het Erasmus MC publiceerden een belangrijke studie: welke vrouwen met hormoongevoelige, uitgezaaide borstkanker hebben op welk moment baat bij tumorgroeiremmers?
Voor meer bewustzijn onder patiënten en professionals hebben ILC-organisaties 15 oktober uitgeroepen tot wereldwijde ILC dag. Het UMC Utrecht organiseert daarom een online avond webinar. Er zijn sprekers uit het onderzoek en de zorg.

Het is alweer 11 jaar geleden dat ik de diagnose borstkanker heb gekregen. Tijdens mijn ziekteperiode en erna heb ik samen met Stijn gepraat over hoe hij zich heeft gevoeld. Daar is het boek Mama uit ontstaan.